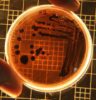

„Мениджър за един ден“ в община Разлог
Разложки ученици „седнаха“ на столовете на управляващия екип на Община Разлог чрез мащабната образователна програма „Мениджър за един ден“
Ранното кариерно ориентиране е безценен опит. “Мениджър за един ден” е най-значимата програма у нас за младежи над 16 години. В рамките на един ден участниците се запознават с реалната работна среда в компании и организации от цялата страна и получават безценно вдъхновение от топ мениджъри.
В инициативата през годините са участвали хиляди ученици и студенти, които са прекрачили прага на избрана от тях компания или организация и са се запознали с любима професия или бизнес сектор. „Мениджър за един ден” 2025 се провежда днес в цялата страна.
Вдъхновяваща беше днес срещата на ръководния екип на Община Разлог и ученици от СУ „Братя Петър и Иван Каназиреви“, ПГ по транспорт, Професионална гимназия по МСС, Разложка професионална гимназия „Никола Стойчев“ – участници в инициативата „Мениджър за един ден“.
Учениците имаха възможност да се запознаят с работата на местната администрация, да споделят идеи и да придобият ценен опит в управлението на общинските процеси.
Участниците се разделиха по интереси в четири мениджърски позиции: Кмет на община Разлог; Зам. -кмет по „Финанси, бюджет и икономика“; Зам.- кмет по „Социални дейности, образование, култура, спорт и туризъм“; Зам. -кмет по „Устройство на територията, строителството и регионалното развитие“.
Те научиха много за отговорностите на ръководния екип, за необходимостта от професионална подготовка и експертиза, за личностните умения, комуникативност, увереност за постигане на цели и отстояване на позиция, гъвкавост за адаптиране към промени и нови идеи, както и надеждност за изграждане на доверие.
Други важни качества, които споделиха екипът на учениците са способността за управление на стреса, мотивация на екипа, търпение и способност за решаване на проблеми.
Радостен е фактът, че млади и мотивирани хора от община Разлог проявяват интерес към работата на местната власт и работата на местната администрация, добиха опит и вдъхновение за бьдещото ви професионално развитие.
Всички участници получиха сертификат „Мениджър за един ден“.
Ранното кариерно ориентиране е безценен опит. “Мениджър за един ден” е най-значимата програма у нас за младежи над 16 години. В рамките на един ден участниците се запознават с реалната работна среда в компании и организации от цялата страна и получават безценно вдъхновение от топ мениджъри.
В инициативата през годините са участвали хиляди ученици и студенти, които са прекрачили прага на избрана от тях компания или организация и са се запознали с любима професия или бизнес сектор. „Мениджър за един ден” 2025 се провежда днес в цялата страна.
Вдъхновяваща беше днес срещата на ръководния екип на Община Разлог и ученици от СУ „Братя Петър и Иван Каназиреви“, ПГ по транспорт, Професионална гимназия по МСС, Разложка професионална гимназия „Никола Стойчев“ – участници в инициативата „Мениджър за един ден“.
Учениците имаха възможност да се запознаят с работата на местната администрация, да споделят идеи и да придобият ценен опит в управлението на общинските процеси.
Участниците се разделиха по интереси в четири мениджърски позиции: Кмет на община Разлог; Зам. -кмет по „Финанси, бюджет и икономика“; Зам.- кмет по „Социални дейности, образование, култура, спорт и туризъм“; Зам. -кмет по „Устройство на територията, строителството и регионалното развитие“.
Те научиха много за отговорностите на ръководния екип, за необходимостта от професионална подготовка и експертиза, за личностните умения, комуникативност, увереност за постигане на цели и отстояване на позиция, гъвкавост за адаптиране към промени и нови идеи, както и надеждност за изграждане на доверие.
Други важни качества, които споделиха екипът на учениците са способността за управление на стреса, мотивация на екипа, търпение и способност за решаване на проблеми.
Радостен е фактът, че млади и мотивирани хора от община Разлог проявяват интерес към работата на местната власт и работата на местната администрация, добиха опит и вдъхновение за бьдещото ви професионално развитие.
Всички участници получиха сертификат „Мениджър за един ден“.